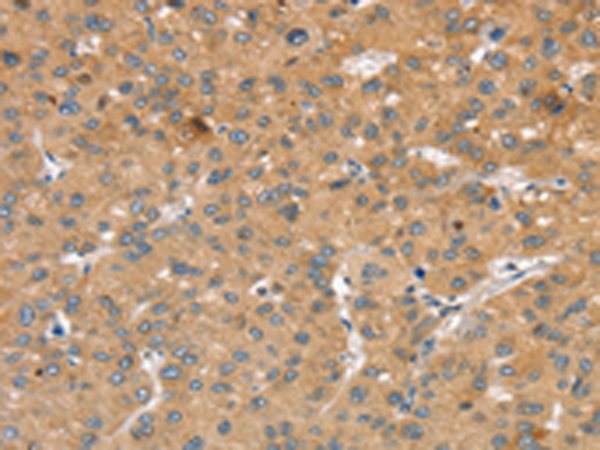
一抗

|
Background: |
This gene encodes a member of the slit family of secreted glycoproteins, which are ligands for the Robo family of immunoglobulin receptors. Slit proteins play highly conserved roles in axon guidance and neuronal migration and may also have functions during other cell migration processes including leukocyte migration. Members of the slit family are characterized by an N-terminal signal peptide, four leucine-rich repeats, nine epidermal growth factor repeats, and a C-terminal cysteine knot. Proteolytic processing of this protein gives rise to an N-terminal fragment that contains the four leucine-rich repeats and five epidermal growth factor repeats and a C-terminal fragment that contains four epidermal growth factor repeats and the cysteine knot. Both full length and cleaved proteins are secreted extracellularly and can function in axon repulsion as well as other specific processes. Alternative splicing results in multiple transcript variants. |
|
Applications: |
ELISA, WB, IHC |
|
Name of antibody: |
SLIT2 |
|
Immunogen: |
Synthetic peptide of human SLIT2 |
|
Full name: |
slit guidance ligand 2 |
|
Synonyms: |
SLIL3; Slit-2 |
|
SwissProt: |
O94813 |
|
ELISA Recommended dilution: |
1000-2000 |
|
IHC positive control: |
Human liver cancer and Human colon cancer |
|
IHC Recommend dilution: |
25-100 |
|
WB Predicted band size: |
170 kDa |
|
WB Positive control: |
Mouse bladder tissue |
|
WB Recommended dilution: |
200-1000 |


 購物車
購物車 幫助
幫助
 021-54845833/15800441009
021-54845833/15800441009